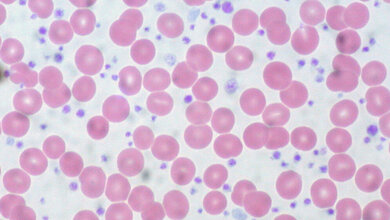
Blutausstrich

Ein Schritt im Kampf gegen die Listeriose
Listerien sind gefürchtet. Die Bakterien können die Krankheit Listeriose hervorrufen, sie kommen vor allem in Lebensmitteln wie Rohfleischerzeugnissen und Rohmilchprodukten vor und führen regelmäßig zu Rückrufaktionen im Handel. Die Letalität liegt laut RKI im Durchschnitt bei 7%. Die Listeriose gehört damit zu den meldepflichtigen Erkrankungen mit der höchsten Letalität. Unter sieben Listeria-Spezies ist L. monocytogenes die weitaus bedeutendste humanpathogene Spezies. Das Bakterium ist zwei Mikrometer groß. Es ist riesig – im Vergleich zu Peptiden. Diese Moleküle sind ähnlich wie Proteine eine Verknüpfung einzelner Aminosäuren, nur sind sie etwas kleiner und sie sind als Wirkstoffe noch nicht so gut erforscht wie die Proteine. Julia Kenzel hat in ihrer Dissertation mit Peptiden neue Möglichkeiten im Kampf gegen Listeria monocytogenes gefunden.
Zwei Peptide blieben übrig
Die Oberfläche des Bakteriums trägt das Protein Internalin. Es geht Verbindungen mit Proteinen auf menschlichen Zellen ein – und genau das machte sich Kenzel zu Nutze: Sie immobilisierte Internalin A im Bioanalytik-Labor der Hochschule Coburg auf einer Mikrotestplatte aus Polystyrol. Dann gab sie eine so genannte Phagenbibliothek hinzu. „Die Phagen tragen auf ihrer Oberfläche eine sehr große Anzahl verschiedener Peptide, die zwölf Aminosäuren lang sind. Sie sind alle potenzielle Bindepartner.” Nach mehreren Schritten blieben zwei Peptide übrig, die spezifisch an Internalin A und darüber auch an ganze Listeria-monocytogenes-Zellen binden. Im Idealfall würde das Peptid so an das Internalin andocken, dass der Krankheitserreger nicht auch noch mit den Proteinen der menschlichen Zelle binden kann. Das könnte eine Infektion verhindern.
Der Coburger Bioanalytik-Professorin Prof. Dr. Susanne Aileen Funke zufolge wurden Phagenbibliotheken bisher gegen ganze Listeria-Zellen eingesetzt, aber nicht gegen ein spezifisches Protein, das nur Listeria monocytogenes besitzt. „Somit könnten die Zellen durch unsere Peptide von anderen pathogenen Bakterien und anderen Listerien-Stämmen unterschieden werden.“ Das Ergebnis der Doktorarbeit sind neue Möglichkeiten, um eine Verunreinigung mit Listerien festzustellen oder um einer Infektion vorzubeugen.
Peptide auf Verpackungen?
„Man könnte die Peptide auf Lebensmittelverpackungen aufbringen. Das Bakterium verbindet sich mit ihnen und lässt sich so aus den Lebensmitteln herausziehen”, sagt Julia Kenzel. Außerdem lassen sich Peptide sehr gut mit Fluoreszenzfarbstoffen markieren. „Damit ließe sich ein Testverfahren entwickeln, das viel schneller wäre als die herkömmliche Zellkulturtechnik, deren Anwendung zwei Wochen dauert.” Potenziell kann auf Basis dieser neuen Forschungsergebnisse auch ein Medikament für Risikogruppen entwickelt werden. Bei Schwangeren, Älteren und Menschen mit geschwächtem Immunsystem endet Listeriose in jedem dritten Fall tödlich. „Es gibt Antibiotika gegen das Bakterium, aber durch ihren vermehrten Einsatz entwickeln sich im Lauf der Zeit Resistenzen.” Kenzel hat einen neuen Ansatz gefunden. Für den Einsatz in der Praxis müssten weitere Untersuchungen im Labor, im Reagenzglas und in Zellkulturen, sowie klinische Studien und die Zulassung als Medikament folgen. „Das ist noch ein langer Weg. Aber die Grundlagen sind gelegt.”
Quelle: idw/Hochschule Coburg
Artikel teilen